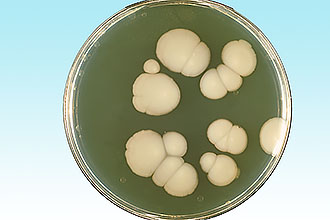

Тонзиллит как основное заболевание
Воспаление небных миндалин, известное также как тонзиллит или ангина, является серьезным заболеванием, требующим внимательного внимания и своевременного лечения.
Если на миндалинах появляются белые точки, но при этом окружающие ткани остаются нетронутыми, можно утверждать, что это ангина грибкового происхождения.
Её развитие зависит от двух основных групп причин, о которых мы подробно поговорим.
Проникновение инфекции
Единственный микроорганизм, вызывающий инфекцию в данном патологическом состоянии, — грибок.
В большинстве медицинских случаев часто обсуждается проблема грибковой инфекции, вызванной грибками рода кандиды. Они присутствуют на слизистых оболочках полости рта, в половых органах, прямой кишке и относятся к условно-патогенной микрофлоре. Почти 100% населения заражено этими грибками, однако не все страдают от их воздействия. Причина заключается в состоянии иммунитета, который играет ключевую роль в подавлении развития грибковых инфекций.
Таким образом, основной целью пациента является поддержание высокого уровня иммунитета, чтобы успешно противостоять атакам грибка, а не только предотвращение заражения (грибок является чрезвычайно заразным).
Грибок может проникать в организм, включая горло, различными способами.
Среди них:
- Распространение через воздушно-капельный путь является одним из основных способов передачи. Это происходит при передаче грибка от человека к человеку через дыхание, чихание и кашель. Частицы слизи и слюны, содержащие кандиду, активно передаются от больного к здоровому человеку, что становится серьезной проблемой для нового носителя.
- Контактно-бытовой способ передачи заключается во взаимодействии с инфицированным человеком, а также через предметы его обихода и личной гигиены. Даже двум знакомым людям рекомендуется использовать свои личные вещи, чтобы избежать передачи возбудителя инфекции. Часто дети в младшем возрасте становятся переносчиками кандидов, поскольку грибки попадают в их организм через грязные руки, соски или при контакте с медицинским персоналом.
- Половой путь, а именно орально-генитальный, также способствует передаче инфекции. Кандиды легко размножаются на слизистых оболочках половых органов. Необходимо применять надежные методы контрацепции, чтобы предотвратить передачу грибков.
- Механический способ передачи инфекции происходит через грязные руки и наиболее распространен среди детей, особенно в младшем возрасте.
- Лимфогенный способ передачи происходит внутри организма с током лимфатической жидкости.
- Трансмиссивный способ передачи инфекции происходит через укусы насекомых.
- Гематогенный способ передачи инфекции происходит с током крови, что позволяет кандидам распространяться по организму и оседать в различных частях тела.
Иммунитет как один их факторов появления белых точек в горле
Защитные силы организма, известные как иммунитет, играют ключевую роль в предотвращении развития вредоносных микроорганизмов.
Опыт демонстрирует, что необходимо уделять особое внимание поддержанию защитных сил организма, иначе существует высокий риск возникновения тонзиллита и других заболеваний. Появление белых точек в горле является признаком ослабления иммунитета.
- Избыточное употребление алкоголя может привести к нарушению местного кровообращения и ожогу горла, что ухудшает иммунитет.
- Длительное курение табака также может вызвать ожог горла, отравление организма и сужение крупных кровеносных сосудов, что снижает иммунитет на общем и местном уровнях.
- У детей раннее отнятие от груди и переход на искусственные смеси может привести к развитию кандидозов, так как это препятствует нормальному формированию защитных сил из-за недостатка необходимых питательных веществ. Также неправильное введение прикорма может повлиять на это.
- Использование оральных контрацептивов без соблюдения дозировок и длительности приема может искусственно увеличить уровень эстрогена в организме, что может вызвать появление пятен и точек белого цвета в горле.
- Избыточное употребление антибактериальных средств, особенно антибиотиков без назначения врача, может негативно сказаться на организме.
- Химиотерапия может подавить развитие клеток иммунной системы, так как цитостатики замедляют их рост, но в некоторых случаях это необходимо.
Защитные силы организма играют решающую роль в предотвращении развития болезней.
Лечение налета и пробок на миндалинах
Необходимо лечить белый налет на миндалинах в зависимости от основной причины, которую можно выявить только после сдачи необходимых анализов, назначенных врачом. Лечение кандидоза слизистых оболочек ротовой полости основывается на использовании лекарств, таких как нистатин, нормализации микрофлоры кишечника и ротовой полости.
Людям, страдающим от частых заболеваний, необходимо избавиться от постоянной инфекции и укрепить работу иммунной системы, чтобы предотвратить появление новых проблем.
При остром тонзиллите часто появляются гнойники на миндалинах. Этот воспалительный процесс сопровождается повышением температуры и сильными симптомами интоксикации. Для предотвращения дальнейшего распространения болезнетворных микроорганизмов необходимо применять антибиотики. Иногда гнойники на миндалинах могут распространиться на окружающие ткани, вызывая их инфицирование. Это осложнение особенно опасно для здоровья, поэтому при выявлении признаков ангины необходимо немедленно обратиться к врачу.
Избавиться от пробок в миндалинах можно обратившись в отоларингологическую клинику.
Обычные сгустки на миндалинах обычно не вызывают особых беспокойств, однако люди всегда стремятся избавиться от них. Поверхностные комочки легко удаляются сами, если немного надавить на ткани миндалин или интенсивно прополоскать горло. Однако не следует насильственно извлекать сгустки, если они находятся в глубине миндалин, поскольку это может способствовать проникновению находящихся в них бактерий внутрь кровотока. Если сгустки различных оттенков периодически появляются на миндалинах, то врачи-лоры рекомендуют воспользоваться несколькими методами их удаления и последующей профилактики.
- Исчезание белых точек на миндалинах можно достичь путем регулярных полосканий горла. Для этого подойдут содово-солевой раствор, отвар ромашки или кора дуба.
- Удаление пробок в миндалинах возможно также в лор кабинете. Специалист может использовать шприц с раствором или специальный аппарат для отсасывания инородных включений.
- При наличии хронического тонзиллита особенно важно полностью вылечить это заболевание.
- Иногда, чтобы окончательно избавиться от часто возникающих пробок, лор врач рекомендует удаление миндалин. Однако прибегать к операции следует только в случае, если другие методы устранения комочков не приносят результатов, а их появление сопровождается неприятным запахом изо рта.
Появление налета на миндалинах, а также образование пробок или других образований, могут быть признаком более серьезных проблем со здоровьем. Для исключения таких проблем необходимо провести своевременное и всестороннее обследование организма.
Что делать при белых пятнах на гландах
Очевидно, забота о здоровье несет важное значение. Мелкие проблемы могут превратиться в серьезные осложнения, например, ангина или стоматит могут негативно отразиться на работе сердечной мышцы. Поэтому всегда рекомендуется обратиться к врачу для консультации.
Если обнаруженные заторы оказались естественным проявлением, связанным с нормальной работой желез, то достаточно проводить обычные процедуры полоскания рта и горла:
- растворами соли и соды;
- травяными отварами;
- антисептическими препаратами;
- настоем коры граната;
- теплой напиток с медом, лимонным соком и соком свёклы.
Имбирь является весьма эффективным средством для укрепления здоровья носоглотки. Существует множество способов использования этого продукта в лечебных целях:
- чай с имбирём и мёдом в любых пропорциях по вашему вкусу, можно добавить немного лимона;
- настой из целебных трав с добавлением имбиря;
- домашний джем с имбирём и мёдом.
Для приготовления этого средства необходимо измельчить 1 кг имбиря вместе с оболочкой любым удобным способом, затем смешать его с таким же объемом меда. Варите смесь на медленном огне в течение трех часов. При простуде или неприятном ощущении першения в горле рекомендуется добавлять по 1 чайной ложке этого средства в чай.
Имбирь является прекрасным средством для укрепления иммунитета.
Возможно, вы можете попробовать удалить его самостоятельно с помощью безопасного предмета (например, чайной ложки), но профессиональный ЛОР-врач справится с этой задачей более эффективно. Также для лечения могут быть использованы ультразвуковая терапия и магнитотерапия.
А не лучше ли совсем убрать миндалины?
Полвека назад это взгляд был распространен. В Америке проводили профилактическое удаление миндалин даже у младенцев.
В ходе исследования было обнаружено, что у людей, у которых удалены гланды, чаще наблюдались следующие проявления:
- чувствительность к раздражителям;
- нарушение пищеварения и микрофлоры желудочно-кишечного тракта;
- заложенность носа;
- воспаление задней стенки горла;
- воспаление околоносовых пазух;
- воспаление легких и бронхов;
- острое респираторное вирусное заболевание;
- и даже злокачественные опухоли верхних дыхательных путей.
Современная точка зрения заключается в том, что удаление миндалин целесообразно только при подтвержденном хроническом сепсисе. У детей младше 5 лет такая процедура не рекомендуется.
Для предотвращения появления белых пятен на гландах можно прибегнуть к традиционным рекомендациям: закаливанию, занятиям физкультурой и отказу от вредных привычек.
Почему появляются белые образования на гландах
Появление белесых пробок на миндалинах обычно вызвано вредоносными микроорганизмами. Чаще всего это:
- бактерии, которые положительно влияют на организм (например, стрептококки, стафилококки)
- грибы из семейства Кандида
- микоплазмы
- бактерия Леффлера
- вирусы
Размножение этих микроорганизмов может быть вызвано некоторыми условиями. Например, переохлаждением или резким падением защитных функций организма. Миндалины, играя роль первичного барьера для патогенных микробов, препятствуют их дальнейшему распространению. На их уровне патогены вызывают местный воспалительный процесс. А налет на миндалинах – это накопление отходов их жизнедеятельности, умерших микроорганизмов, лейкоцитов и других вирусов. При этом возникает неприятный запах изо рта.
Если ребенок активен и не жалуется на ухудшение состояния, то появление белого налета на миндалинах может быть безопасным. Это происходит из-за употребления молочной пищи и скопления остатков еды на слизистой оболочке миндалин. Такой налет обычно исчезает самостоятельно в течение получаса.
Причины налета на миндалинах
В основном, гнойники на миндалинах возникают как дополнительный признак при различных заболеваниях, вызванных вторжением в организм вредных микроорганизмов. Существует несколько состояний, при которых проявляется эта симптоматика.
- Инфекция кандидозом.
- Острое или длительное воспаление миндалин.
- Заболевание дифтерией.
- Воспаление слизистой полости рта.
Если вы заметили белый налет в виде точек, комочков или пробок на поверхности миндалин, важно обратить внимание на сопутствующие клинические признаки хронического или острого тонзиллита, стоматита, кандидоза или дифтерии. В этом случае рекомендуется обратиться к специалисту, который сможет поставить точный диагноз и провести необходимую дифференциальную диагностику.
Сущность белых пробок и симптомы их появления
При лакунарной ангине возникают белые гнойники на миндалинах, которые могут иметь форму пробок или налета. Это сопровождается болями в горле, увеличением лимфоидной ткани и ее гиперемией, а также общей интоксикацией организма, повышением температуры тела и общим недомоганием.
Белые отложения (пробки) на миндалях могут свидетельствовать о наличии хронического тонзиллита. Они образуются из-за накопления остатков пищи, клеток эпителия и патогенных микроорганизмов в лакунах миндалин. Иногда в пробках могут содержаться кальцинированные вещества. Они могут иметь оттенок от светло-белого до бордового.
При хронической форме тонзиллита гнойники на миндалинах могут появляться без повышенной температуры и явных признаков инфекции. Однако образованию пробки на миндалине часто сопутствует ощущение наличия постороннего объекта в горле, неприятный запах изо рта, а также зуд и жжение.
Белые точки на гландах
При поражении слизистой оболочки горла при стоматите возможно появление белого прыща на миндалине или белесоватого налета. Пациент может испытывать неприятные ощущения в области горла, болезненность при глотании, а также увеличение лимфоузлов в этом районе. Через несколько дней налет исчезает, и появляются кровоточащие язвы на слизистой оболочке ткани.
При фолликулярной ангине можно заметить гнойнички на миндалинах в виде точек или зерен. Это заболевание влияет не только на слизистую оболочку миндалин, но также проникает внутрь миндалин, вызывая воспаление фолликул. Болезнь проявляется сильными признаками отравления организма.
Температура тела может подняться до 39-40°. Человека могут беспокоить болезненные ощущения в горле, кашель и першение. Также возможны проблемы с пищеварительной системой, такие как рвота, тошнота и нарушение стула. Облегчение наступает, когда белые гнойные шарики на миндалинах прорываются, и гной выходит в полость рта.
Белесые комочки в гландах
Часто можно заметить наличие белого налета на миндалинах, который напоминает сгустки творога или белые комочки. Это может свидетельствовать о развитии дрожжеподобного грибка из рода Кандида на поверхности миндалин. Эта патология обычно не сопровождается ярко выраженными симптомами. У пациента могут возникать ощущения дискомфорта в области горла, а также сухость и жжение на слизистой оболочке.
Более опасным состоянием, при котором возникает белый прыщ на гланде или их множество в области горла, является дифтерия. У пациента наблюдается тяжелая интоксикация организма, с повышением температуры и болями в горле. К диагностическим признакам развития дифтерии относят образование бело-серого налета, который трудно снимается, оставляя после себя кровоточащие эрозии.
Функция миндалин
Человеческое тело защищено кожным покровом от патогенов, которые могут проникнуть из окружающей среды. Единственные открытые точки контакта с внешней средой — полость рта и носа. При разговоре и дыхании воздух активно поступает внутрь организма, перенося с собой мельчайшие частицы и газообразные вещества, а также нежелательную микрофлору.
Миндалины играют важную роль в защите организма от различных инфекций.
Роль «таможенников», тщательно изучающих и обезвреживающих состав пищи и вдыхаемого воздуха, исполняют гланды (по латыни это — железа), они же миндалины. Второе их название носит описательный характер: по внешнему виду они напоминают миндальную косточку. Хотя, если вглядеться в них основательнее, можно обнаружить большее сходство с ядром грецкого ореха — они имеют очень глубокие извилины (лакуны), намного увеличивающие поверхность гланд.
Миндалины, входящие в состав кольца Пирогова-Вальдейера, представляют собой группу лимфоидных образований, которые фильтруют и очищают воздушный поток в области носоглотки. Это кольцо эффективно задерживает до 70% патогенных микроорганизмов, которые могут проникнуть в организм. Поэтому неудивительно, что на миндалинах часто образуются белые отложения в различных объемах.
Миндалины играют крайне важную роль для организма, поскольку:
- защищают организм от инфекции;
- подогревают и увлажняют вдыхаемый воздух;
- их полости ─ это места, где организм распознает врага и производит клетки-фагоциты, поглощающие возбудителей, а также специальные антитела в крови;
- кроме этого, железы также влияют на общий иммунитет организма, хотя этот процесс ещё не до конца изучен.
Природа образования белых пятен в гландах
Появление белых пятен на миндалинах может свидетельствовать о наличии инфекции.
При борьбе с инфекцией в лакунах (они же крипты) накапливается органический материал, включая остатки пищи, зубной налёт, отшелушившиеся клетки эпителия и метаболиты бактерий. Эти компоненты образуют мягкие отложения в криптах, которые снаружи проявляются как белые пятна на миндалинах, зачастую не сопровождающиеся повышением температуры и ухудшением самочувствия.
Если миндалина не справляется с агрессивной инфекцией, то она воспаляется, это состояние называется тонзиллит острый или хронический. Миндалины становятся болезненными, увеличиваются в размерах, перекрывая дыхательные пути, на их поверхности образуются множественные гнойные пробки, возникает неприятный запах изо рта. Повышается температура, появляются и другие признаки интоксикации организма. Хотя и одиночная гнойная пробка может принести немало страданий. Такое воспаление миндалин называется лакунарной ангиной.
Когда отдельные лимфатические фолликулы на поверхности гланд воспаляются, симптомы будут выглядеть как скопление белых пятен на покрасневшем основании. Это состояние известно как фолликулярная ангина и доставляет боль большое дискомфорт.
Болезнь часто возникает из-за сопутствующих неблагоприятных условий или наличия долгосрочных очагов инфекции, таких как:
- зубов с кариесом;
- патологически увеличенных десневых карманов при воспалении десен;
- постоянного насморка;
- воспаления пазух носа;
- затрудненного носового дыхания из-за искривления перегородки носа.
Белые пятна ─ признак многих болезней
Обнаружение белых отложений на миндалинах, изображения которых легко найти в интернете, может указывать на различные здоровотворные нарушения.
Для людей, употребляющих табак, это может свидетельствовать о развитии лейкоплакии ─ предракового состояния, за появление которого отвечает только вредная привычка, от которой необходимо немедленно избавиться.
Пониженный уровень иммунитета может привести к развитию стоматита как у взрослых, так и у детей. Этот вид заболевания может иметь вирусную, бактериальную или грибковую природу. При различных формах стоматита миндалины не являются основным местом поражения, вместо этого затрагивается вся слизистая оболочка. Новые элементы на щеках или губах часто остаются незамеченными из-за своего расположения, в то время как белое пятно на миндалине сразу бросается в глаза ─ что это?
Грибковая инфекция в полости рта, известная как стоматит кандидозного происхождения, особенно часто встречается у младенцев в первые месяцы жизни и у людей, которые часто принимают антибиотики. Афтозный или язвенный стоматиты имеют ярко выраженные симптомы с характерными признаками на слизистой оболочке полости рта и общими признаками отравления организма.
Определение возбудителя является необходимым этапом при обнаружении стоматита, поскольку различные его виды требуют различных подходов к лечению.
Дифтерия
В современные времена, к счастью, очень редко встречаются белые пятна на миндалинах у ребёнка, вызванные таким опасным заболеванием как дифтерия. Они быстро объединяются в плёнку, срастающуюся с эпителием, но легко отторгаются затем с образованием эрозии. Эти отторгшиеся плёнки при попадании в дыхательные пути могут привести к асфиксии и смерти. До середины ХХ века дифтерия была распространена. В настоящее время детям делают от неё прививки.
Возможно заболеть и у взрослых. Поэтому если возникают внезапные проблемы со здоровьем, такие как тошнота, двоение в глазах, высыпания на коже и затрудненное дыхание, необходимо обратиться за помощью к медицинским экспертам.
Лечение в медицинском учреждении
Обычно госпитализации требуют пациенты с серьезной формой ангины, инфекционным мононуклеозом, подозрением на дифтерию и гнойно-септическими осложнениями. Также стационарное лечение обязательно рекомендуется для детей до года или живущих в неблагоприятных социально-бытовых условиях.
При лечении бактериальных тонзиллитов применяют следующие методы:
- Препараты, уничтожающие бактерии широкого спектра (например, пенициллины, защищенные пенициллины, цефалоспорины и макролиды), такие как Флемоксим, Аугментин, Цефуроксима аксетил, Азитромицин или Кларитромицин.
- Средства для обеззараживания горла в форме растворов для полоскания, леденцов, таблеток или спреев (например, Гевалекс, Тантум-Верде, Лисобакт, Граммидин).
- Для детей рекомендуется использовать полоскания фурацилиновым или содовым раствором. Не рекомендуется применение спреев.
- Препараты-антигистаминные для подавления аутоиммунного воспаления (например, Супрастин, Лоратадин, Цетиризин).
При серьезном протекании заболевания используют инфузионную терапию (глюкозу, солевые растворы), внутривенные иммуноглобулины и препараты для снижения температуры тела.
При возникновении тонзилломикоза у взрослых применяются системные противогрибковые средства в форме таблеток или растворов для внутривенного введения. Необходимы полоскания с антимикотиками и антисептиками.
Во время беременности достаточно сложно подобрать безопасный для будущего малыша препарат. В большинстве случаев врачи рекомендуют применение антибиотиков из группы пенициллинов, а также использование полосканий, что не вызывает негативных последствий.
При лечении простого инфекционного мононуклеоза доктор Комаровский рекомендует использовать симптоматическую терапию. Поскольку это вирусное заболевание, то антибактериальные препараты не всегда необходимы. Важно тщательно очищать полость рта, контролировать температуру тела и следовать предписанному врачом режиму.
После удаления налетов с миндалин возможно применение физиотерапевтического лечения. Наиболее эффективным методом считается тубус-кварц – местное ультрафиолетовое облучение, обладающее бактерицидными свойствами.
Грибковое поражение
Активация грибков, которые могут вызывать заболевания, может привести к развитию грибковых инфекций. Чаще всего обнаруживается размножение кандидальных грибов, но в редких случаях (около 5%) обнаруживаются плесневые грибы. Появление способности вызывать заболевания у грибков обусловлено:
- ослаблением защитных функций организма из-за обострения серьезных заболеваний, таких как онкологические заболевания, туберкулез и ОРВИ;
- продолжительным применением гормональных препаратов, антибиотиков в больших количествах, длительным курсом лечения;
- воздействием лучевой и химиотерапии.
Клинический кандидозный тонзиллит часто проявляется незаметными симптомами. Для диагностики обычно применяется эндоскопическое исследование. При фарингоскопии можно обнаружить белые пятна на задней стенке горла и миндалинах, похожие на налеты. Также грибковый процесс может затронуть слизистую оболочку щек и языка. Эти налеты легко удаляются с поверхности слизистой оболочки.
Для подтверждения диагноза необходимо провести микологическое исследование, которое поможет выявить возбудителей инфекции и определить их чувствительность к лекарствам. Лечение направлено на устранение причины заболевания и назначение препаратов против грибковой инфекции (например, Интраконазол, Флуконазол).
При разговоре о кандидозном фарингите, его симптомы обычно включают:
- ощущением дискомфорта, жжением и першением в области горла;
- появлением сухости и неприятного запаха;
- умеренной болезненностью, которая усиливается при употреблении пищи с пряностями;
- наличием субфебрильной гипертермии (встречается крайне редко).
В настоящее время грибковое поражение часто обнаруживается среди заболеваний отоларингологического профиля. Из-за разнообразия клинических и морфологических особенностей выделяют несколько разновидностей фарингомикоза:
- формирование налетов бело-желтого оттенка;
- появление гиперемированных зон с лакированной поверхностью;
- образование белых бляшек, которые трудно удалять;
- образование язвенных дефектов на поверхности глоточной слизистой.
Во время фарингоскопии обнаруживается отечность слизистой, белое пятно в области горла и налеты. Очаги поражения в основном располагаются на миндалинах, стенке глотки и дужках. Налеты имеют белый оттенок и сгущенную текстуру. Они легко удаляются, но иногда могут оставлять кровоточащую поверхность.
Когда кандидозный процесс распространяется на окружающие ткани, это может привести к поражению гортани, пищевода и языка. Важно провести дифференциальную диагностику с дифтерией. Неэффективное лечение увеличивает риск образования абсцесса в ротоглотке и развития сепсиса.
Госпитализация необходима в случае осложненного грибкового фарингита. Лечение включает в себя системную противогрибковую терапию. Также проводится местное лечение, включающее полоскание, промывание миндалин и глоточной стенки антисептическими растворами (например, Мирамистин, Клотримазол).
Ключевым моментом в успешном лечении грибкового поражения является укрепление иммунной системы и борьба с begleitenden тяжелой патологией.
Предотвращение поражения миндалин и горла включает в себя соблюдение гигиены ротовой полости, регулярную очистку хронических инфекционных очагов в области носа и горла, укрепление иммунитета, правильное питание, своевременное лечение сопутствующих заболеваний и отказ от курения. При соблюдении этих рекомендаций можно не только предотвратить заболевания ЛОР-органов, но и общим образом укрепить свое здоровье.
Способы лечения
При возникновении белых точек из-за тонзиллита, лечение включает в себя два основных этапа:
- использование препаратов, борющихся с бактериями и снижающих воспаление;
- методы, облегчающие проявление признаков заболевания;
- применение средств для укрепления иммунитета и добавление витаминов в рацион.
Среди лекарственных средств, наиболее часто используемых при лечении тонзиллита, можно выделить препараты с антивоспалительным эффектом, такие как Парацетамол, Анальгин, Ибупрофен. В эту категорию также входят рассасывающие таблетки (например, Фарингосепт) и спреи (например, Гексорал).
Избавиться от белых точек на миндалинах можно путем полоскания горла. Для этого рекомендуется использовать теплый раствор соды с солью или раствор Фурацилина.
Также можно воспользоваться специальными растворами для полоскания (например, Ротокан, календула). Эти средства оказывают более сильное воздействие, чем рассасывающие таблетки, однако они могут быть неудобны для детей, у которых болит горло, поскольку полоскание может вызвать затруднения.
Дополнительные методы, которые могут облегчить симптомы заболевания, включают рекомендации врача по изменению образа жизни и диеты. Например, рекомендуется употреблять больше теплых напитков и других жидкостей (за исключением кислых соков), употреблять только мягкую пищу, которую легко глотать, чтобы не нагружать ослабленное горло.
Народные рецепты
Самый распространенный метод борьбы с ангиной в народной медицине – использование ингаляций. Они эффективно облегчают боль и раздражение в горле, эффективно очищают слизистую оболочку. Ингаляции представляют собой отличную альтернативу полосканиям, которые часто вызывают трудности у детей.
Использование настоя ромашки для ингаляций
Понадобится:
- алкоголь – полстакана;
- мед – одна ложка для столовых приборов;
- цветы ромашки (можно приобрести в аптеке) – 20 г;
- вода – поллитра.
Начнем с приготовления настоя для ингаляций: зальте ромашку водой, поставьте на огонь и доведите до кипения. Затем поместите кастрюлю с получившимся настоем на удобный стул или стол, и вдыхайте пары, укрытые плотным полотенцем.
Продолжительность ингаляции составляет от двадцати до тридцати минут. Не рекомендуется осуществлять данную процедуру при повышенной температуре тела.
Напиток из ореха грецкого
Понадобится:
- требуется три столовые ложки измельченных грецких орехов;
- три столовые ложки натурального меда;
- половина стакана воды.
Раздробленные перегородки смешивают с медом и доводят до кипения. Затем смесь оставляют настаиваться в течение двух часов. Принимать лекарство следует, разбавляя его водой (по одной чайной ложке на стакан) три раза в день.
Перед использованием любых методов народной медицины, необходимо обязательно получить консультацию у медицинского специалиста.
Частые вопросы
Что представляют собой белые точки на миндалинах?
Белые точки на миндалинах могут быть камнями миндалин, или так называемыми миндалинами. Это образования, состоящие из остатков пищи, бактерий и других материалов, которые могут скапливаться в углублениях миндалин.
Каковы причины образования белых точек на миндалинах?
Причины образования белых точек на миндалинах могут быть связаны с неправильным уходом за полостью рта, бактериальной инфекцией, а также с повышенным содержанием кальция или мочевины в слюне.
Как происходит лечение белых точек на миндалинах?
Лечение белых точек на миндалинах может включать в себя промывание миндалин, прием антибиотиков при бактериальной инфекции, а также в некоторых случаях хирургическое удаление миндалин.
Полезные советы
СОВЕТ №1
Обратитесь к отоларингологу для точного диагноза и назначения лечения. Белые точки на миндалинах могут быть признаком различных заболеваний, поэтому важно получить профессиональную консультацию.
СОВЕТ №2
Избегайте самолечения. Не пытайтесь выдавливать или удалять белые точки на миндалинах самостоятельно, так как это может привести к инфекции и ухудшению состояния.
СОВЕТ №3
Следите за гигиеной полости рта. Регулярно чистите зубы, используйте зубную нить, полоскайте рот антисептическими средствами и избегайте переедания, чтобы уменьшить риск образования белых точек на миндалинах.









